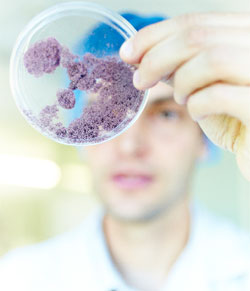

Bretagne Développement Innovation et Capbiotek, la dynamique régionale au service du développement et de la promotion des biotechnologies, annoncent la progression de la Bretagne avec l’intégration de deux nouvelles entreprises sur la BioMap. La région confirme ainsi sa troisième position au palmarès national. Identifiées comme un axe prioritaire dans la stratégie de développement économique régionale, les biotechnologies sont également très soutenues par le secteur privé.
Bretagne Développement Innovation et Capbiotek, la dynamique régionale au service du développement et de la promotion des biotechnologies, annoncent la progression de la Bretagne avec l’intégration de deux nouvelles entreprises sur la BioMap. La région confirme ainsi sa troisième position au palmarès national. Identifiées comme un axe prioritaire dans la stratégie de développement économique régionale, les biotechnologies sont également très soutenues par le secteur privé.
Pour la deuxième année consécutive, la Bretagne est en 3e position nationale
Pour maintenir cette position d’excellence, derrière les régions Ile-de-France et Rhône-Alpes, la Bretagne capitalise sur ses ressources naturelles exceptionnelles et des compétences uniques. 1ère région française pour les biotechnologies marines, elle est également un acteur majeur dans les agro-biotechs.
Cette année, la BioMap recense 26 entreprises biotechs en Bretagne répondant aux critères de Biotech Finances :
![]() région ;
région ;
![]() être détenteur d’une technologie propriétaire ;
être détenteur d’une technologie propriétaire ;
![]() afficher un chiffre d’affaires de l’année en cours + subventions et levées de fonds (depuis l’origine) supérieur à 1M€ ;
afficher un chiffre d’affaires de l’année en cours + subventions et levées de fonds (depuis l’origine) supérieur à 1M€ ;
![]() accepter la diffusion de ses données par Biotech Finances.
accepter la diffusion de ses données par Biotech Finances.
Les 26 entreprises : Agrimer, Agrival, Algues & Mer, BioMerieux, Biopredic, Bioprojet Biotech, BiotechMarine, Biotrial, BIO3G, Bretagne Plants, C.Ris Pharma, Codif international, Diafir, Eurosafe, Goëmar, Hemarina, HTL, Javenech, Kelia, ManRos Therapeutics, NG Biotech, Nutrialys Medical Nutrition, Olmix, Polaris, Polymaris Biotechnology, Soliance, Yslab.
Le Crédit Agricole prêt à soutenir les projets biotechnologiques bretons Témoin de la confiance placée dans ce secteur, le Crédit Agricole du Finistère a créé en 2014 un fonds dédié à la filière Mer, afin d’investir notamment dans les projets biotechs prometteurs qui émergent régulièrement sur le territoire breton.
Cet événement, inscrit dans le cadre de Capbiotek et à l’initiative du club d’entreprises Bretagne Biosciences, est co-organisé par CBB Capbiotek, ID2Santé, le Pôle Mer Bretagne Atlantique et Bretagne Développement Innovation.